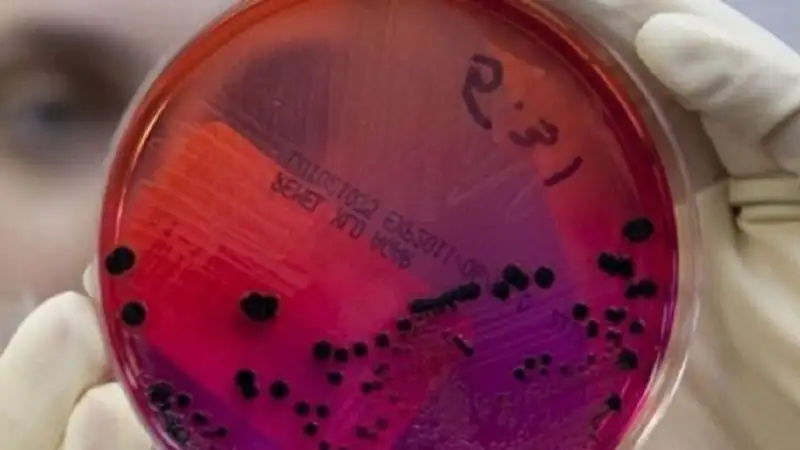
В Алматы дома строят в зонах захоронения сибирской язвы

Язва сибирская: почему захоронения очаговой инфекции в Казахстане до сих пор бесхозные?
 Фото: Zakon.kz/Екатерина Гуляева
Фото: Zakon.kz/Екатерина Гуляева
Сибирская язва относится к очаговым инфекциям. Вспышки заболеваемости ею ежегодно фиксируются по всему Казахстану. Ученые считают, что споры сибирской язвы могут сохранять свою активность до ста лет. Поэтому к очагам, где были ранее выявлены вспышки болезни, или к местам захоронения больных животных следует относиться с повышенным вниманием. Однако в Казахстане в этом отношении ситуация далеко не безупречна.
За последние пять лет по всей стране наблюдается динамика роста опасной болезни. К примеру, в 2019 году было зарегистрировано 12 случаев заражения людей сибирской язвой, в 2020 году – 4, в 2021 году – 27 фактов, в 2022 году – 20, в 2023 – 37.
Жетысуская область
В Жетысуской области случаи заражения сибирской язвой в последний раз фиксировались в 2016 году в Кербулакском районе. Тогда три фермера заболели кожной формой сибирской язвы. Была проведена проверка, и как выяснилось, корова, которую разделывали мужчины, не была инфицирована. И источника болезни ветеринары выявить так и не смогли.
Между тем в ходе расследования сотрудники надзорного органа региона выявили вопиющий случай халатности местных исполнительных органов.
"В подвальном помещении сельского округа Сарыбулак Кербулакского района были обнаружены более 30 тысяч ампул с вакциной сибирской язвы. Но по документам препараты были списаны после использования по назначению. Получается, что животные, для которых они предназначались, были привиты только на бумаге", – сообщил тогда начальник Управления прокуратуры Алматинской области Сабит Чембеков.
Тогда же, в 2016 году, был поднят вопрос о создании карты сибиреязвенных скотомогильников и их окрестностей по всей стране. В Алматинской области (до 2022 года Жетысуская область была в ее составе. – Прим. ред.) пересчитали опасные зоны и определили 271 очаг.
"После определения очагов сибирской язвы – всего их 230 – внесли в топографическую государственную кадастровую книгу и автоматическую систему госкадастра", – подчеркнул руководивший в тот период Алматинским областным управлением ветеринарии Аскар Нурбаев.
На календаре уже 2024 год, однако на территории Жетысуской области до сих пор 33 захоронения очагов сибирской язвы не приняты на баланс государства. Кроме того, меры по их изолированию до сих пор не приняты. Как давно эти участки находятся без присмотра, а главное – когда над ними будет осуществляться надлежащий контроль, неизвестно. Поделиться более подробной информацией в природоохранной прокуратуре не сочли нужным. Единственное, что удалось выяснить, это места, где они находятся, – Аксуский и Сарканский районы.
Мониторингом ситуации с сибирской язвой также занимаются сотрудники областного департамента санэпидконтроля. По их данным, эта зоонозная инфекция чаще всего поражает травоядных животных. Бактерии выделяют очень сильные токсины, которые в большинстве случаев смертельны. Люди могут заразиться этим заболеванием от инфицированных животных через сырое молоко, мясо и продукты его переработки.
"В нашем регионе зафиксировано 97 стационарно неблагополучных пунктов по сибирской язве и 134 почвенных очага. На сегодняшний день с помощью GPS-навигатора определены их координаты и вывешены знаки с надписью "Сибирская язва". Мониторинг почвенных очагов сибирской язвы нашими специалистами проводится регулярно. За 2023 год исследовано 790 проб почвы, положительных не выявлено. Также в прошлом году против сибирской язвы вакцинировано 618 лиц из группы риска. Это работники убойных и мясоперерабатывающих предприятий, организаций по переработке шкур и шерсти животных, врачи и персонал ветеринарных клиник, сотрудники лабораторий, занимающихся диагностикой и исследованием инфекции", – сообщила заместитель руководителя Департамента СЭК Жетысуской области Индира Кунбасова.
Также она пояснила, что стационарно неблагополучные территории – это не только населенные пункты, где ранее был зарегистрирован падеж скота. Это могут быть точечные участки. Например, жилой дом, где жил заболевший человек, или сарай, где хранились шкуры больных животных. Почвенными очагами называют места захоронений останков домашнего скота в неблагополучном пункте. Контроль за соблюдением всех норм безопасности лежит на ветеринарных службах.
Кызылординская область
В Кызылординской области насчитывается 146 скотомогильников. Но не все объекты типовые, ветеринарным стандартам соответствуют 90 из них. Остальные – это примитивные ямы. Каждый год в регионе строят по несколько типовых, но могильников до сих пор не хватает.
Ветеринары области проводят профилактику домашнего скота по 14 опасным заболеваниям. Это сибирская язва, бешенство, чума, пастереллез, птичий грипп, бруцеллез, мыт и другие болезни.
Но скот все же заболевает. Чтобы изменить ситуацию в лучшую сторону, в 2023 году в области сдали бюджетную заявку на 60 млн тенге для строительства трех скотомогильников в аулах Казалинского района. Разработана проектно-сметная документация на строительство 7 скотомогильников в селах. Сейчас в области не хватает 56 таких объектов.
Восточно-Казахстанская область
В Восточном Казахстане из 101 сибиреязвенного захоронения 95 функционируют с нарушениями, среди которых – расположение жилых домов и пастбищ рядом с опасными участками, а также отсутствие ограждений возле могильников.
Именно к такому выводу пришли представители Антикоррупционной службы ВКО, проверив захоронения для животных. Ситуация покажется еще более удручающей, если учесть, что область всегда считалась природным очагом сибирской язвы. И волноваться есть о чем, поскольку известны случаи гибели людей от тяжелого заболевания. В 2018 году в Восточном Казахстане от сибирской язвы погиб 47-летний житель Катон-Карагайского района. Было установлено, что источником заражения как раз и стал скотомогильник – сибиреязвенное захоронение 1972 года. Находилось оно в 5 километрах от места, где забивали скот сельчане. Тогда местные власти отреагировали достаточно оперативно, предприняв все меры, чтобы не допустить распространение заболевания. Вот только мужчину не удалось спасти.
Однако навести полный порядок в содержании опасных могильников за годы, прошедшие с момента трагедии, до сих пор так и не удалось. Это в очередной раз подтвердила проверка.
"Нарушения в основном касались соблюдения санитарно-защитной зоны, но в 19 случаях захоронения находились в непосредственной близости к жилым домам и соцобъектам. Более того, акиматы под пастбища выдавали участки, которые находились в санитарно-защитной зоне", – рассказали в Антикоррупционной службе ВКО.
Кроме того, было обнаружено, что в ВКО не все места захоронений огорожены. В Тарбагатайском районе жилой дом находился всего в 250 метрах от неогороженного сибиреязвенного захоронения, а в Курчумском и вовсе рядом находилась школа. Ежедневно дети занимались всего в 650 метрах от опасного места, хотя в санитарно-эпидемиологических требованиях четко оговаривается, что подобные скотомогильники относятся к первому классу опасности, а значит, санитарно-защитная зона должна составлять не менее 1-го км.
"Проблемы в этой сфере имеются, причем они глубже, чем может показаться. В некоторых населенных пунктах области вообще нет никаких скотомогильников – не только сибиреязвенных. Обеспеченность специально оборудованных мест захоронения для животных сегодня составляет всего 70%", – пояснили в Управлении сельского хозяйства ВКО.
Сегодня в Восточном Казахстане имеется 101 сибиреязвенное захоронение и 156 скотомогильников, из них 140 – типовые, 116 – биотермические ямы. На их содержание ежегодно выделяется более 10 млн тенге. Но в регионе планируют построить еще несколько. Только до 2025 года появится 45 типовых скотомогильников.
На данный момент закончено строительство оборудованных мест для захоронения животных в селах Катон-Карагайского района на 105 млн тенге, выделено более 18,5 млн тенге на разработку ПСД 19-ти скотомогильников для Самарского, Тарбагатайского, Зайсанского, Самарского и Уланского районов.
Абайская область – мнения экспертов
"Споры возбудителя могут годами существовать в почве, сохраняя жизнеспособность и патогенные свойства. Они представляют собой потенциальный источник инфекции для животных, а значит, и людей. Труп животного, павшего от сибирской язвы, – наиболее значимый фактор передачи инфекции, так как содержит большое количество сибиреязвенных бацилл и заражает почву", – рассказала Марал Нуркенова, кандидат ветеринарных наук Семипалатинского университета им. Шакарима.
Поэтому, по ее мнению, так важно проводить своевременные профилактические мероприятия, в которых участвуют медицинские, ветеринарные службы, хозяйственно-административные органы.
"Основной причиной ежегодных случаев и вспышек заболеваемости сибирской язвой людей является неконтролируемый подворный убой скота и реализация мяса населению, проживающему в активных очагах сибирской язвы. Заболевание животных связано с отсутствием вакцинации против сибирской язвы или применением некачественной вакцины", – подчеркнула Марал Нуркенова.
По ее мнению, надзор за опасной инфекцией должен носить комплексный характер – это выявление, учет, паспортизация и постоянное отслеживание санитарно-ветеринарного состояния и проявлений эпизоотической или эпидемиологической активности неблагополучных по сибирской язве сел.
"Недаром говорят: если медицинский врач лечит человека, то ветеринарный – человечество. Потому что медицинский врач изучает и лечит только организм человека. А в компетенции ветеринара – лечение и профилактикаэ́ заболеваний домашних и диких животных, птиц и даже насекомых. Ведь они могут попасть на стол к человеку", – убежден доктор ветеринарных наук, профессор Зейнолла Токаев.
По словам ученого, раньше в области существовала практика ежеквартального анализа текущей эпизоотической ситуации совместно со специалистами зооветеринарного и медицинского институтов.
"Мы проводили подробный мониторинг по каждому случаю инфекционного заболевания людей, и не только сибирской язвы. Это причины заболевания, источники заражения, район распространения инфекции, зона возможного проникновения. Когда на эти вопросы находили ответы, мы рекомендовали, как устранять причины инфекции, уничтожали источники распространения, проводили массовые профилактические мероприятия". Зейнолла Токаев
Например, в 1987 году Зооветеринарный институт в Семипалатинске стал научным центром координации по проблемам туберкулеза в масштабах всей страны.
В регионе долгое время работал профессор Виктор Федосеев. Исследуя состояние здоровья людей, животных и птиц в ряде сельских районов области, он установил у них наличие так называемой "L-формы". Это и есть возбудитель туберкулеза. Но врачи, не зная источников этой инфекции, лечили больных, возвращая их в ту же среду, где продолжали находиться животные – носители болезни. При этом людей лечили малоэффективными препаратами от другого возбудителя туберкулеза. Эти лекарства слабо реагировали на истинную причину болезни. Таким образом, полностью вылечить людей было просто невозможно.
На основе исследований, проведенных профессором и его командой, была разработана новая методика лечения и профилактики туберкулеза. Лечили одновременно и людей, и животных. В результате были достигнуты поразительные результаты: очаг заболевания удалось полностью ликвидировать.
"То же самое можно сказать и о сибирской язве. Заболевание известно с древнейших времен, и с тех пор наверняка можно было принять какие-то меры для борьбы с инфекцией. А если не получается, значит, есть естественные, природные очаги ее развития, и дикие животные, а также насекомые становятся разносчиками ее спор", – отметил Зейнолла Токаев.
По его мнению, основным методом профилактики этой болезни остается своевременная вакцинация животных и людей из группы риска. Кроме того, крайне важно соблюдать санитарно-гигиенические правила при работе с животными: использовать спецодежду, перчатки, респиратор, а также правильно мыть руки.
"Не стоит покупать мясо, если есть сомнения в его происхождении. Я, например, всегда требую у продавца соответствующие документы. И, увы, не всегда они есть в наличии. Это говорит о многом", – отметил Зейнолла Токаев.
Ветеринарно-санитарные правила, принятые в Казахстане
Крайне важно своевременно и в соответствии со всеми правилами утилизировать туши больных животных и тела людей.
Так, например, захоронения людей, умерших от сибирской язвы, проводятся с соблюдением требований противоэпидемического режима с использованием дезсредств в оцинкованном, герметически запаянном гробу. Для рытья могил, перевозки, погребения тела комплектуется группа из 3-5 человек. И захоронение происходит на отдельном участке, который позже обязательно огораживается.
Что касается утилизации больных животных, то приказом министра сельского хозяйства в 2015 году в Казахстане были утверждены ветеринарно-санитарные правила, в которых специально оговаривались требования к скотомогильникам или биотермическим ямам. Согласно им, скотомогильники должны размещаться на сухом возвышенном участке земли с уровнем стояния грунтовых вод не менее двух метров от поверхности земли. Территорию скотомогильника огораживают глухим забором высотой не менее двух метров с въездными воротами. При этом с внутренней стороны забора по всему периметру выкапывают траншею глубиной 0,8-1,4 метра и шириной не менее 1,5 метра, через которую перекидывают мост.
Правилами особо оговаривается, что скотомогильники не размещают в водоохранной, лесопарковой и заповедной зонах. Их по всему периметру огораживают металлической или бетонной изгородью высотой не менее 1,5 метра, исключающей доступ людей и животных, с табличкой "Сибирская язва" и датой возникновения болезни.
Трупы павших животных, а также продукцию и сырье сжигают в специальных установках. Зольный остаток помещают в ямы Беккари – специальное сооружение с крышкой, в котором стены и дно изолированы водонепроницаемым материалом, вокруг ямы располагается траншея и двухметровый забор. Без заборов и крышек такие ямы могут стать легкодоступными для птиц и животных.
"Место вынужденного убоя, вскрытия трупа животного, павшего от сибирской язвы, тщательно обжигают, затем обливают 20%-ным раствором хлорной извести, почву перекапывают на глубину 25 сантиметров и перемешивают с сухой хлорной известью из расчета одна часть извести на три части почвы, содержащей не менее 25% активного хлора. После перемешивания с известью почву увлажняют водой", – говорится в ветеринарно-санитарных правилах.
"Вы видите, насколько это важная работа. По данным ВОЗ, установлено более 150 заболеваний, общих для человека и животных. 124 из этого списка сегодня обнаружены на территории нашей страны. И любой здравомыслящий человек скажет: "Не вылечив животных, можно ли оздоровить человека?" – задается вопросом профессор Зейнолла Токаев.
Значит, пока к ветеринарии не будет такого же серьезного отношения, как и к медицине, большого эффекта можно не ждать.